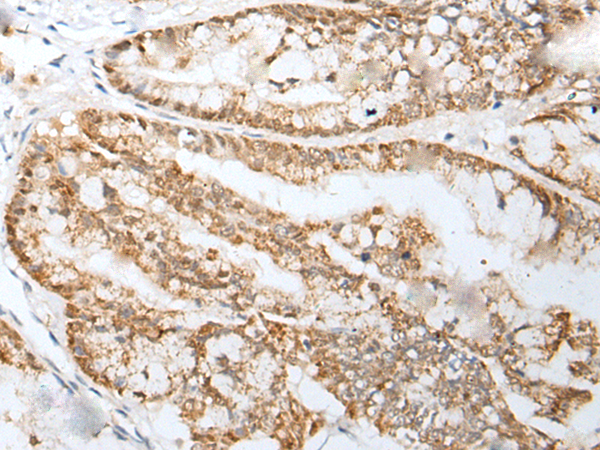

中文名稱:兔抗AR多克隆抗體
|
Background: |
The androgen receptor gene is more than 90 kb long and codes for a protein that has 3 major functional domains: the N-terminal domain, DNA-binding domain, and androgen-binding domain. The protein functions as a steroid-hormone activated transcription factor. Upon binding the hormone ligand, the receptor dissociates from accessory proteins, translocates into the nucleus, dimerizes, and then stimulates transcription of androgen responsive genes. This gene contains 2 polymorphic trinucleotide repeat segments that encode polyglutamine and polyglycine tracts in the N-terminal transactivation domain of its protein. Expansion of the polyglutamine tract causes spinal bulbar muscular atrophy (Kennedy disease). Mutations in this gene are also associated with complete androgen insensitivity (CAIS). Two alternatively spliced variants encoding distinct isoforms have been described. |
|
Applications: |
ELISA, IHC |
|
Name of antibody: |
AR |
|
Immunogen: |
Synthetic peptide of human AR |
|
Full name: |
androgen receptor |
|
Synonyms: |
KD; AIS; AR8; TFM; DHTR; SBMA; HYSP1; NR3C4; SMAX1; HUMARA |
|
SwissProt: |
P10275 |
|
ELISA Recommended dilution: |
5000-10000 |
|
IHC positive control: |
Human colorectal cancer and human liver cancer |
|
IHC Recommend dilution: |
25-100 |

購物車
購物車 幫助
幫助
 021-54845833/15800441009
021-54845833/15800441009
